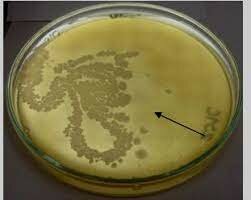
Se introduce en la microbiologia el concepto de antagonismo

-
Abarca desde la antigüedad hasta los primeros microscopistas
-
 Se debe a Constantijn Huygens, quien relata que el inglés Cornelis Drebbel tenía en su taller un instrumento magnificador, que recibió el nombre de microscopium en 1625, en la Accademia dei Lincei, de Roma.
Se debe a Constantijn Huygens, quien relata que el inglés Cornelis Drebbel tenía en su taller un instrumento magnificador, que recibió el nombre de microscopium en 1625, en la Accademia dei Lincei, de Roma. -
 Athanasius Kircher con ayuda de un adecuado microscopio compuesto, habría visto bacterias, que también son células, describiéndolas en la sangre de enfermos de peste como unas culebrillas o pequeñísimos gusanillos.
Athanasius Kircher con ayuda de un adecuado microscopio compuesto, habría visto bacterias, que también son células, describiéndolas en la sangre de enfermos de peste como unas culebrillas o pequeñísimos gusanillos. -
Robert Hooke publicó en 1665, Micrographia el primer libro dedicado a la descripción de las observaciones hechas a través del microscopio. También se le atribuye la introducción del término “célula”.
-
 Sus actividades son conocidas por la humanidad desde muy antiguo, tanto las beneficiosas, representadas por las fermentaciones implicadas en la producción de bebidas alcohólicas, pan y derivados lácteos, como las perjudiciales, en forma de enfermedades infecciosas. Diversas fuentes escritas de la antigüedad griega y romana hablan de gérmenes invisibles que transmiten enfermedades contagiosas.
Sus actividades son conocidas por la humanidad desde muy antiguo, tanto las beneficiosas, representadas por las fermentaciones implicadas en la producción de bebidas alcohólicas, pan y derivados lácteos, como las perjudiciales, en forma de enfermedades infecciosas. Diversas fuentes escritas de la antigüedad griega y romana hablan de gérmenes invisibles que transmiten enfermedades contagiosas. -
 El descubrimiento de los microorganismos fue obra de un comerciante holandés de tejidos, Antonie van Leeuwenhoek, quien fabricó unos cuatrocientos microscopios simples, con los que llegó a obtener aumentos de casi 300 diámetros. En 1675 descubrió que en una gota de agua de estanque pululaba una asombrosa variedad de pequeñas criaturas a las que denominó "animálculos". En 1683 descubre las bacterias, por lo que se considera el "padre de la Microbiología".
El descubrimiento de los microorganismos fue obra de un comerciante holandés de tejidos, Antonie van Leeuwenhoek, quien fabricó unos cuatrocientos microscopios simples, con los que llegó a obtener aumentos de casi 300 diámetros. En 1675 descubrió que en una gota de agua de estanque pululaba una asombrosa variedad de pequeñas criaturas a las que denominó "animálculos". En 1683 descubre las bacterias, por lo que se considera el "padre de la Microbiología". -
Tiene sus inicios cerca de 1675 y llega hasta mediados del 1800.
-
 Antonie van Leeuwenhoek descubre las bacterias, por lo que se considera el "padre de la Microbiología".
Antonie van Leeuwenhoek descubre las bacterias, por lo que se considera el "padre de la Microbiología". -
Se inicia con el desarrollo de cultivos de microorganismos y termina en 1899. La microbiología se convierte en una ciencia asentada.
-
 Agostino Bassi demostró que cierta enfermedad del gusano de seda, que había hecho su aparición en Lombardía, se debía a un hongo. Cuatro años más tarde J.L. Schönlein descubrió la asociación de un hongo con una enfermedad humana de la piel.
Agostino Bassi demostró que cierta enfermedad del gusano de seda, que había hecho su aparición en Lombardía, se debía a un hongo. Cuatro años más tarde J.L. Schönlein descubrió la asociación de un hongo con una enfermedad humana de la piel. -
Theodor Schwann presentó un método seguro para refutar la teoría abiogénica: calentó maceraciones en frascos a los que se había eliminado previamente el aire, pero no continuó trabajando en esta línea.
-
 Ignaz Semmelweis, médico austriaco que logró dar con la causa que generaba la fiebre puerperal en mujeres y recién nacidos tras los partos. Descubrió que la tasa de mortalidad era más alta en las mujeres que eran atendidas por los estudiantes de medicina en comparación con aquellas que eran atendidas por parteras. Tras un seguimiento pudo darse cuenta de que los estudiantes se trasladaban del departamento de autopsia al de maternidad sin lavar sus manos.
Ignaz Semmelweis, médico austriaco que logró dar con la causa que generaba la fiebre puerperal en mujeres y recién nacidos tras los partos. Descubrió que la tasa de mortalidad era más alta en las mujeres que eran atendidas por los estudiantes de medicina en comparación con aquellas que eran atendidas por parteras. Tras un seguimiento pudo darse cuenta de que los estudiantes se trasladaban del departamento de autopsia al de maternidad sin lavar sus manos. -
 Por otro lado, el médico inglés John Snow, conocido como pionero de la epidemiología, realizó una investigación con respecto al cólera en épocas de la epidemia en Europa. Logró descubrir que el modo de transmisión de esta enfermedad era a través del agua contaminada.
Por otro lado, el médico inglés John Snow, conocido como pionero de la epidemiología, realizó una investigación con respecto al cólera en épocas de la epidemia en Europa. Logró descubrir que el modo de transmisión de esta enfermedad era a través del agua contaminada. -
 Louis Pasteur demostró que los agentes de la fermentación láctica eran microorganismos, trabajando sobre un problema que había surgido entre los destiladores de Lille cuando en sus cubas la fermentación alcohólica se vio sustituida por una indeseable fermentación láctica. Este fue el inicio de una larga serie de estudios que habría de durar hasta 1876, en los que Pasteur identificó distintos microorganismos responsables de diferentes clases de procesos fermentativos
Louis Pasteur demostró que los agentes de la fermentación láctica eran microorganismos, trabajando sobre un problema que había surgido entre los destiladores de Lille cuando en sus cubas la fermentación alcohólica se vio sustituida por una indeseable fermentación láctica. Este fue el inicio de una larga serie de estudios que habría de durar hasta 1876, en los que Pasteur identificó distintos microorganismos responsables de diferentes clases de procesos fermentativos -
Louis Pasteur resolvió la cuestión a favor de la teoría biogénica y demostró que el líquido no desarrollaba microorganismos, con lo que eliminó la posibilidad de que un "aire alterado" fuera la causa de la no aparición de gérmenes. Antes bien, comprobó que los gérmenes del aire quedaban retenidos a su paso por el largo cuello sinuoso, en las paredes del tubo, y no alcanzaban el interior del recipiente donde se encontraba la infusión, quedando ésta estéril indefinidamente.
-
 Louis Pasteur adscribe inequívocamente la fermentación alcohólica a ciertos tipos de levaduras, y en 1866, en sus Études sur le vin resume sus hallazgos al respecto, inaugurando la Microbiología Aplicada, una de las primeras derivaciones prácticas no empíricas emanadas de la Biología.
Louis Pasteur adscribe inequívocamente la fermentación alcohólica a ciertos tipos de levaduras, y en 1866, en sus Études sur le vin resume sus hallazgos al respecto, inaugurando la Microbiología Aplicada, una de las primeras derivaciones prácticas no empíricas emanadas de la Biología. -
Louis Pasteur publica un informe en el que explica cómo se pueden capturar los "cuerpos organizados" del aire con ayuda de un tubo provisto de un tapón de algodón como filtro, y la manera de recuperarlos para su observación microscópica. De esta forma quedaba definitivamente aclarado el origen de los microorganismos, y se abría la Edad de Oro del estudio científico de las formas de vida no observables a simple vista.
-
 La intervención de bacterias como agentes específicos en la producción de enfermedades fue descubierta a raíz de una serie de investigaciones sobre el carbunco o ántrax, enfermedad que afecta a ganado y que puede transmitirse al hombre. C. Davaine, encontró que en la sangre de vacas afectadas aparecían grandes cantidades de microorganismos a los que llamó bacteridios además, logró inducir la enfermedad experimentalmente en vacas sanas, inoculándoles muestras de sangre infectada.
La intervención de bacterias como agentes específicos en la producción de enfermedades fue descubierta a raíz de una serie de investigaciones sobre el carbunco o ántrax, enfermedad que afecta a ganado y que puede transmitirse al hombre. C. Davaine, encontró que en la sangre de vacas afectadas aparecían grandes cantidades de microorganismos a los que llamó bacteridios además, logró inducir la enfermedad experimentalmente en vacas sanas, inoculándoles muestras de sangre infectada. -
 Lord Joseph Lister, cirujano inglés conocido como el padre de la cirugía antiséptica, desarrolló un sistema para el tratamiento antiséptico de heridas. Además ideó la forma de crear un ambiente libre de microorganismos dentro del quirófano a través del uso de determinados agentes químicos y físicos.
Lord Joseph Lister, cirujano inglés conocido como el padre de la cirugía antiséptica, desarrolló un sistema para el tratamiento antiséptico de heridas. Además ideó la forma de crear un ambiente libre de microorganismos dentro del quirófano a través del uso de determinados agentes químicos y físicos. -
El médico inglés W. Roberts describió las propiedades antibióticas de ciertos cultivos de hongos (Penicillium glaucum) contra las bacterias, e introdujo en Microbiología el concepto de antagonismo.
El médico inglés W. Roberts describió las propiedades antibióticas de ciertos cultivos de hongos (Penicillium glaucum) contra las bacterias, e introdujo en Microbiología el concepto de antagonismo. -
 Robert Koch, quien con su reciente técnica de cultivo puro logró, el primer aislamiento y propagación in vitro del bacilo del ántrax, consiguiendo las primeras microfotografías sobre preparaciones secas, fijadas y teñidas con azul de metileno.
Robert Koch, quien con su reciente técnica de cultivo puro logró, el primer aislamiento y propagación in vitro del bacilo del ántrax, consiguiendo las primeras microfotografías sobre preparaciones secas, fijadas y teñidas con azul de metileno. -
 John Tyndall aplicó el sistema de esterilización por calentamiento discontinuo (hoy conocida precisamente como tindalización), que evidenció la existencia de formas microbianas de reposo muy resistentes al calor, lo cual fue confirmado poco más tarde por Ferdinand Cohn al descubrir las esporas bacterianas.
John Tyndall aplicó el sistema de esterilización por calentamiento discontinuo (hoy conocida precisamente como tindalización), que evidenció la existencia de formas microbianas de reposo muy resistentes al calor, lo cual fue confirmado poco más tarde por Ferdinand Cohn al descubrir las esporas bacterianas. -
Lister realizó diluciones secuenciales de cultivos mixtos, hasta lograr muestras en las que existía una sola célula. Gracias al descubrimiento de la relación entre los gérmenes y las enfermedades, se pudieron realizar avances en la cirugía y el manejo de los padecimientos. Es así como se implementaron medidas de esterilización y cuarentena.
-
 Koch realiza la primera propuesta del concepto de especie dentro del mundo bacteriano.
Koch realiza la primera propuesta del concepto de especie dentro del mundo bacteriano. -
-
-
 Hans Cristian Joachim Gram introdujo la tinción que lleva su nombre. Este tipo de tinción, supuso un gran avance en la observación inicialmente y la clasificación posterior de las bacterias.
Hans Cristian Joachim Gram introdujo la tinción que lleva su nombre. Este tipo de tinción, supuso un gran avance en la observación inicialmente y la clasificación posterior de las bacterias. -
-
-
-
-
-
 Buchner obtuvo, a partir de levaduras, una preparación enzimática que era capaz de realizar la misma transformación de "fermentación" que las células vivas. Las fermentaciones eran procesos químicos catalizados por enzimas presentes dentro de células vivas, que podían ser estudiados extracelularmente. De esta forma, la Bioquímica, nacida como una rama de la química fisiológica, que se venía especializando en la enzimología, encontró una alianza fructífera y duradera con la joven Microbiología.
Buchner obtuvo, a partir de levaduras, una preparación enzimática que era capaz de realizar la misma transformación de "fermentación" que las células vivas. Las fermentaciones eran procesos químicos catalizados por enzimas presentes dentro de células vivas, que podían ser estudiados extracelularmente. De esta forma, la Bioquímica, nacida como una rama de la química fisiológica, que se venía especializando en la enzimología, encontró una alianza fructífera y duradera con la joven Microbiología. -
Tiene sus inicios a comienzos del 1900, cuando los especialistas abordan a los microorganismos desde diversos ángulos como la genética, la ecología, la bioquímica y fisiología.
Los descubrimientos en Europa ayudaron a sentar las bases de la microbiología en América. A partir de esta época se realizaron múltiples avances en el área de la medicina, con la que se desarrollaron algunas sustancias imprescindibles de la actualidad como los antibióticos. -
-
-
-
 Fleming atribuyo a una sustancia química concreta (la penicilina) la acción inhibidora sobre bacterias producida por el hongo Penicillium notatum. Fleming desarrolló un ensayo crudo para determinar la potencia de la sustancia en sus filtrados, pudiendo seguir su producción a lo largo del tiempo de cultivo, y mostrando que no todas las especies bacterianas eran igualmente sensibles a la penicilina.
Fleming atribuyo a una sustancia química concreta (la penicilina) la acción inhibidora sobre bacterias producida por el hongo Penicillium notatum. Fleming desarrolló un ensayo crudo para determinar la potencia de la sustancia en sus filtrados, pudiendo seguir su producción a lo largo del tiempo de cultivo, y mostrando que no todas las especies bacterianas eran igualmente sensibles a la penicilina. -
Looking for a timeline maker?
Create timelines for projects, roadmaps, history, lessons, legal cases, and stories with Timetoast. Timetoast is a timeline maker for work, school, research, and stories.